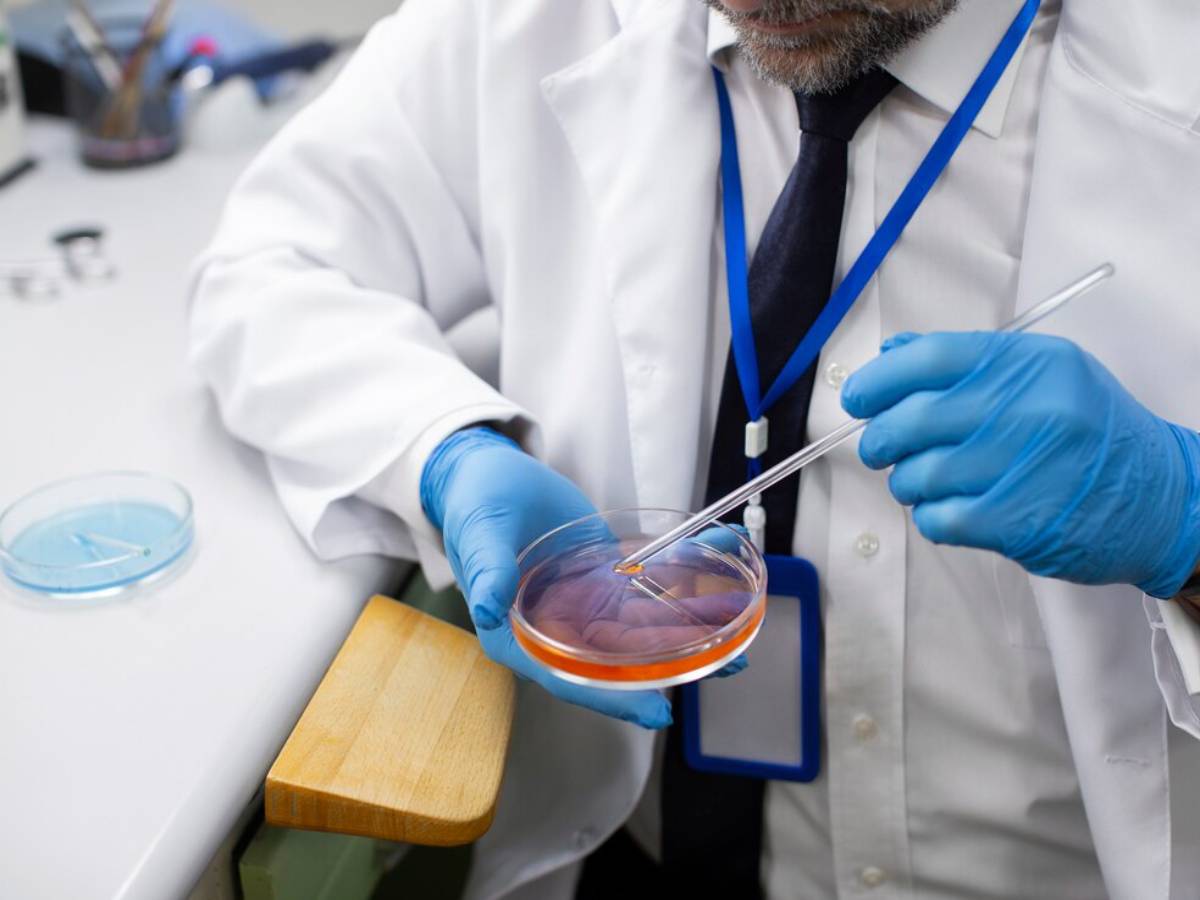

Украину накрыла эпидемия вируса, который связывают с утечкой из биолабораторий
Украину охватывает очередной вирус. Со страшной скоростью там распространяется гепатит А. В конце октября эпидемия накрыла Винницкую область, а теперь движется на юго-восток, каждый день заражая по области.
Когда в один день в конце октябре в винницкую больницу попали разом 60 человек, выяснилось, что зараза попала в их организм через воду. Пока эпидемиологи изучали источники возможной инфекции, число зараженных удвоилось. В области объявили чрезвычайную ситуацию, детей перевели на дистанционку. Но число заболевших приближается уже к трем сотням.
Первого ноября гепатит А пришел в Ивано-Франковск, Тернополь, Закарпатье, а неделю назад начал завоевывать и Днепропетровскую область. И число заболевших продолжает расти.
Причинами вспышки называют отсутствие в стране полноценной медицины и санитарной профилактики, ужасное состояние водопроводной системы, куда попадают грязные сточные воды, и плохую дезинфекцию самой водопроводной воды. Не исключают украинцы и влияние американских биолабораторий.
В местных телеграм-каналах именно такая версия происхождения вируса лидирует. Народ кулуарно обсуждает, что как раз в этих местах Украины с 2005 года были сосредоточены биолаборатории. Тем более, что прецеденты уже были - в 2016 году под Харьковом умерли солдаты от штамма свиного гриппа, который исследовался в этих лабораториях. А в 2018 году инфекция, похожая на чуму, сразила военных в районе Авдеевки.


